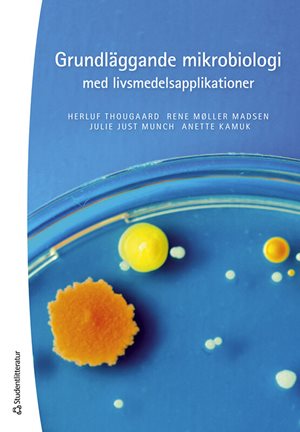
ISBN 9789144181417 Grundläggande mikrobiologi med livsmedelsapplikationer

Aktiva filter (0)
BiologiNaturvetenskap och miljö - Kurslitteratur

Fogelfors, Håkan (red.)
Växtodling är grunden för all livsmedelproduktion. Den är startpunkt för både växter och djur, och med hjälp av växtodlingen fångas solenergi in, u...

Thougaard, Herluf m.fl.
Hur orsakar mikroorganismer sjukdomar som matförgiftning, ebola, borrelia och bandmask? Och hur utnyttjas mikroorganismer som Saccharomyces, E.coli...
Thougaard, Herluf m.fl.
Hur orsakar mikroorganismer sjukdomar som matförgiftning, ebola, borrelia och bandmask? Och hur utnyttjas mikroorganismer som Saccharomyces, E.coli...
Ny upplaga
Prisbelönt
Kurslitteraturpriset

Carlson, Karin m.fl.
Vi lever i mikroorganismernas värld! Mikroorganismerna finns överallt omkring oss och uppvisar en oanad mångfald. De påverkar oss och våra liv på e...

Carlson, Karin m.fl.
Vi lever i mikroorganismernas värld! Mikroorganismerna finns överallt omkring oss och uppvisar en oanad mångfald. De påverkar oss och våra liv på e...

Sjöman, H - Slagstedt, J
Vikten av grönska i våra städer kan inte överskattas. Speciellt är vackra välmående träd en förutsättning för att såväl människor som djur ska triv...

Sjöman, H - Slagstedt, J (red.)
Med rätt träd på rätt plats och situation är mycket vunnet. Vikten av grönska i våra städer kan inte överskattas. Speciellt är vackra välmående tr...

Lundberg, Gunilla A.
Spektrofotometri, kromatografi och elektrofores är några grundläggande laboratorievetenskapliga tekniker som beskrivs i boken. Syftet är att förmed...


Widén, M - Widén, B (red.)
Boken ger en bred översikt över växtvärlden och dagens syn på växternas inbördes släktskap. Det nya växtsystemet presenteras frikostigt med de fles...

Gärdenfors, Ulf m.fl.
Svensk småkrypsfauna är en bestämningshandbok till Sveriges ryggradslösa djur utom insekter. Med dess hjälp kan man identifiera bl.a. snäckor och m...

Widén, Marie
Boken omfattar huvudsakligen artbeskrivningar med detaljerade illustrationer av våra vildväxande träd och buskar. Inledningsvis ges en bestämnings...
Allt har laddats in!
11 av 11